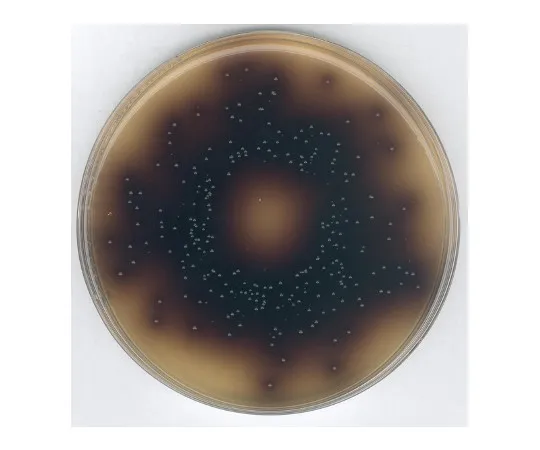

Analyzer, Testing Equipment
61-0205-44 Bile Salt Esculin Azide Agar Medium (ISO 7899-2 Compliance) for Microbiology 100072 500G 1.00072.0500
Product Description
Product Model: 61-0205-44Product Brand: Merck Millipore […]
Contact Us
Product Details
Product Model: 61-0205-44
Product Brand: Merck Millipore Corporation
Spec
- Product number: 100072
- ※We ask for your kind understanding that lead time might change If it is out of stock in Japan.
Related product recommendations
You may also be interested in the following products
61-4430-24 Glass Base for Φ47mm 061680-4721
model: 61-4430-24
brand: SIBATA SCIENTIFIC TECHNOLOGY LTD.
62-8460-70 Anti-CUX1 (a.a. 861) ABE217
model: 62-8460-70
brand: Sigma Aldrich Japan(Millipore)
62-8480-75 EmbryoMax(R) Embryonic Stem Cell Line - Strain 129/SVEV, passage 11; 2 vials CMTI-1
model: 62-8480-75
brand: Sigma Aldrich Japan(Millipore)
62-8371-66 Anti-FAK, clone 4.47; 200 μg 05-537
model: 62-8371-66
brand: Sigma Aldrich Japan(Millipore)